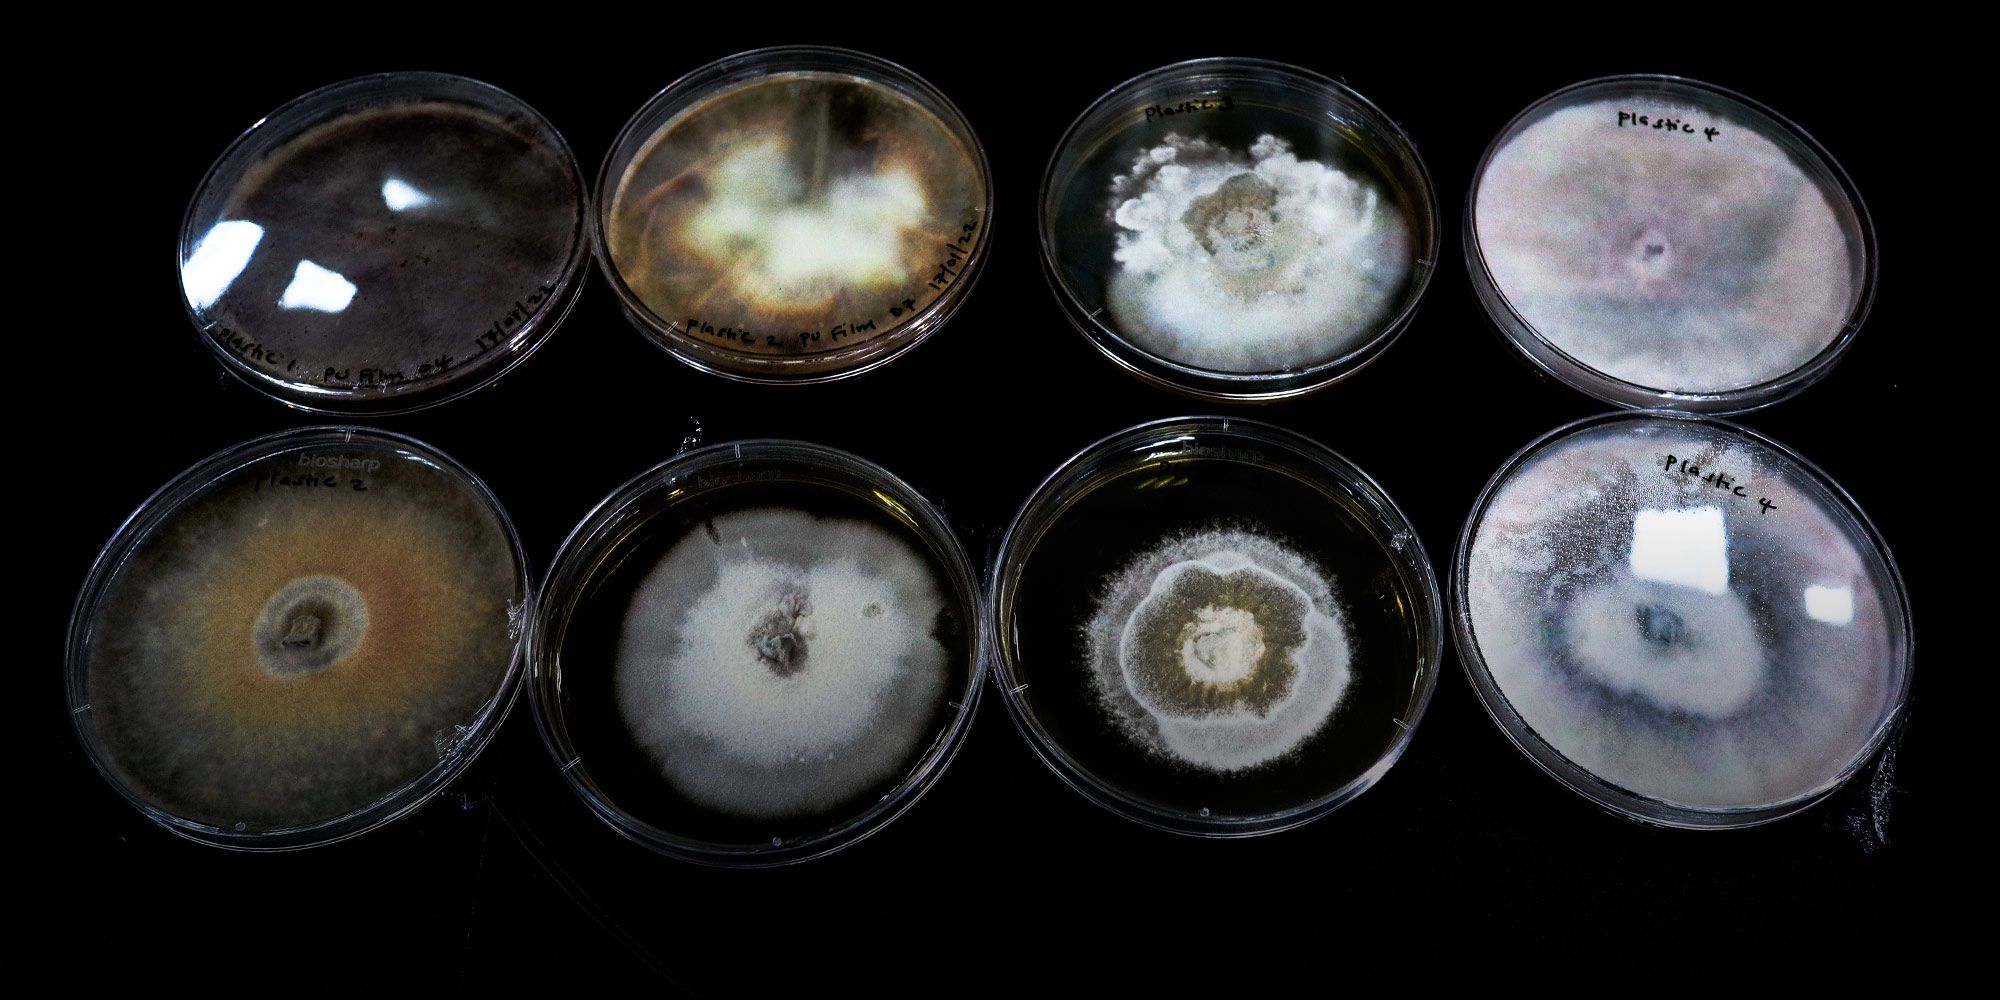

RSS bot
shared a link post in group #Sixth Tone Fans 📸
www.sixthtone.com
A Yunnan Researcher’s Plan for Plastic Waste: Feed It to the Fungi
Newly discovered fungi in Southwest China are voracious eaters of plastic and rubber. Scientists hope they can provide better ways of recycling plastics.
